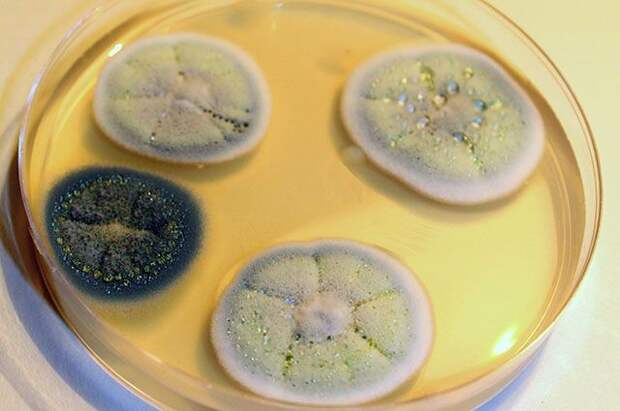

Великий и ужасный пенициллин, как и некоторые другие эффективные антибиотики, сегодня, увы, практически бесполезен — микробы и бактерии давно к нему приспособились. Ученые недавно объявили о новых лекарства, сопоставимых с ними по мощности.
История гласит, что впервые действие пенициллина опробовали в 1940 г.
на лондонском констебле — он поранил угол рта шипом розы из букета, который поднес своей невесте. Общего заражения крови тогда удалось избежать благодаря уколам чуда-средства, выделенного из грибка-кистевика (или пенициллюма).К сожалению, тот констебль все равно умер. По одной из версий, потому что тогда не хватало опыта применения нового антибиотика. По другой — потому что не хватило запасов нового препарата. Промышленный выпуск пенициллина был налажен только в 1943 году в США, куда была передана технология получения нового лекарства.
Но уже в победном 1945 г. трем создателям пенициллина (Александру Флемингу, Говарду Флори и Эрнсту Чейну) была присуждена Нобелевская премия. Американские репортеры тогда писали, что их вклад в Победу равносилен участию в боях 25 дивизий, — свойства пенициллина изучали в буквальном смысле на фронтах, на раненых солдатах. Действие нового препарата сравнивали с эффектом волшебной палочки — введение пенициллина предупреждало нагноение ран и заражение крови, а после лечения им в строй возвращалось около 70% раненых.
В мирное время пенициллин стал одной из причин секс-революции 60-х, поскольку уничтожил страх людей перед сифилисом. Существует легенда о краже итальянской мафией нескольких грузовиков с упаковками пенициллина — для защиты высадившихся в 1943 г.
на Сицилию бойцов от сифилиса.Вскоре после войны был разработан второй антибиотик — стрептомицин, который показал высокую эффективность в борьбе с туберкулезом. За его создание тоже вручили Нобелевскую премию спустя семь лет, в 1952 году.
В 1965 году был выделен третий чудо-антибиотик — рапамицин, который назвали в честь его месторождения — острова Пасхи (Рапануи на местном наречии).
Поначалу были известны только антибактериальные и противогрибковые свойства рапамицина. Позже он совершил революцию в клеточной биологии. С его помощью был открыт большой протеиновый комплекс, названный ТОР, или «Таргет Оф Рапамицин», блокирование которого останавливает деление клеток и, как обещают, старение (во всяком случае мышам с помощью рапамицина удалось существенно продлить жизнь).
В чем сила, брат?
Однако сегодня все чаще говорят не о мощи антибиотиков, а о нечувствительности микромира к некогда великим и ужасным препаратам. Где только не искали ученые достойную альтернативу: в пре- и в пробиотиках и даже в косточках грейпфрута.
Однако ни одно новое средство не помогало.
Не так давно было объявлено о создании новых препаратов и технологий, сопоставимых по мощи с некогда могучими антибиотиками.
О чем идет речь? Рассказывает кандидат биологических наук Игорь Лалаянц:
1. Циклические фибупептиды
В университетах Тюбингена и Геттингена синтезировали циклические фибупептиды (цепочки аминокислот). Это новый класс антибиотиков, который убивает бактерии, нарушая их энергетический обмен. Фибупептиды работают против особо опасных метициллин-резистентных бактерий вида Staphylococcus aureus (MRSA), одного из самых распространенных и опасных для человека микроорганизмов из-за его высокой заразности и способности к формированию нечувствительности к антибиотикам.
2. Ген- редактирование
На фоне возобновившегося патентного спора между университетами Гарварда и Беркли (пригород Сан-Франциско), ген-редактирование набирает обороты. Оно позволяет исправлять самые разные гены с помощью фермента, «подводимого» к ним с помощью молекул РНК-гидов. Компания Чан (Chan), жены Цукерберга, предложила новый вариант метода, названный FLASH — вспышка, озарение. Его преимущество в синтезе многочисленных РНК-гидов, что повышает эффективность и нацеленность редактирования. Метод успешно опробован на четырех пациентах с устойчивой к антибиотикам пневмонией и пяти с малярией, что открывает путь к клиническим испытаниям. В начале июля сотрудники Медицинского колледжа А.Эйнштейна в Нью-Йорке сообщили в Nature, что им удалось с помощью редактирования полностью «вычистить» геном иммунных клеток мышей от ДНК-копий вирусных РНК вируса иммунодефицита. Возможно, что их метод также может применяться у людей, в геноме которых много «ненужных» ДНК различных вирусов.
Свежие комментарии